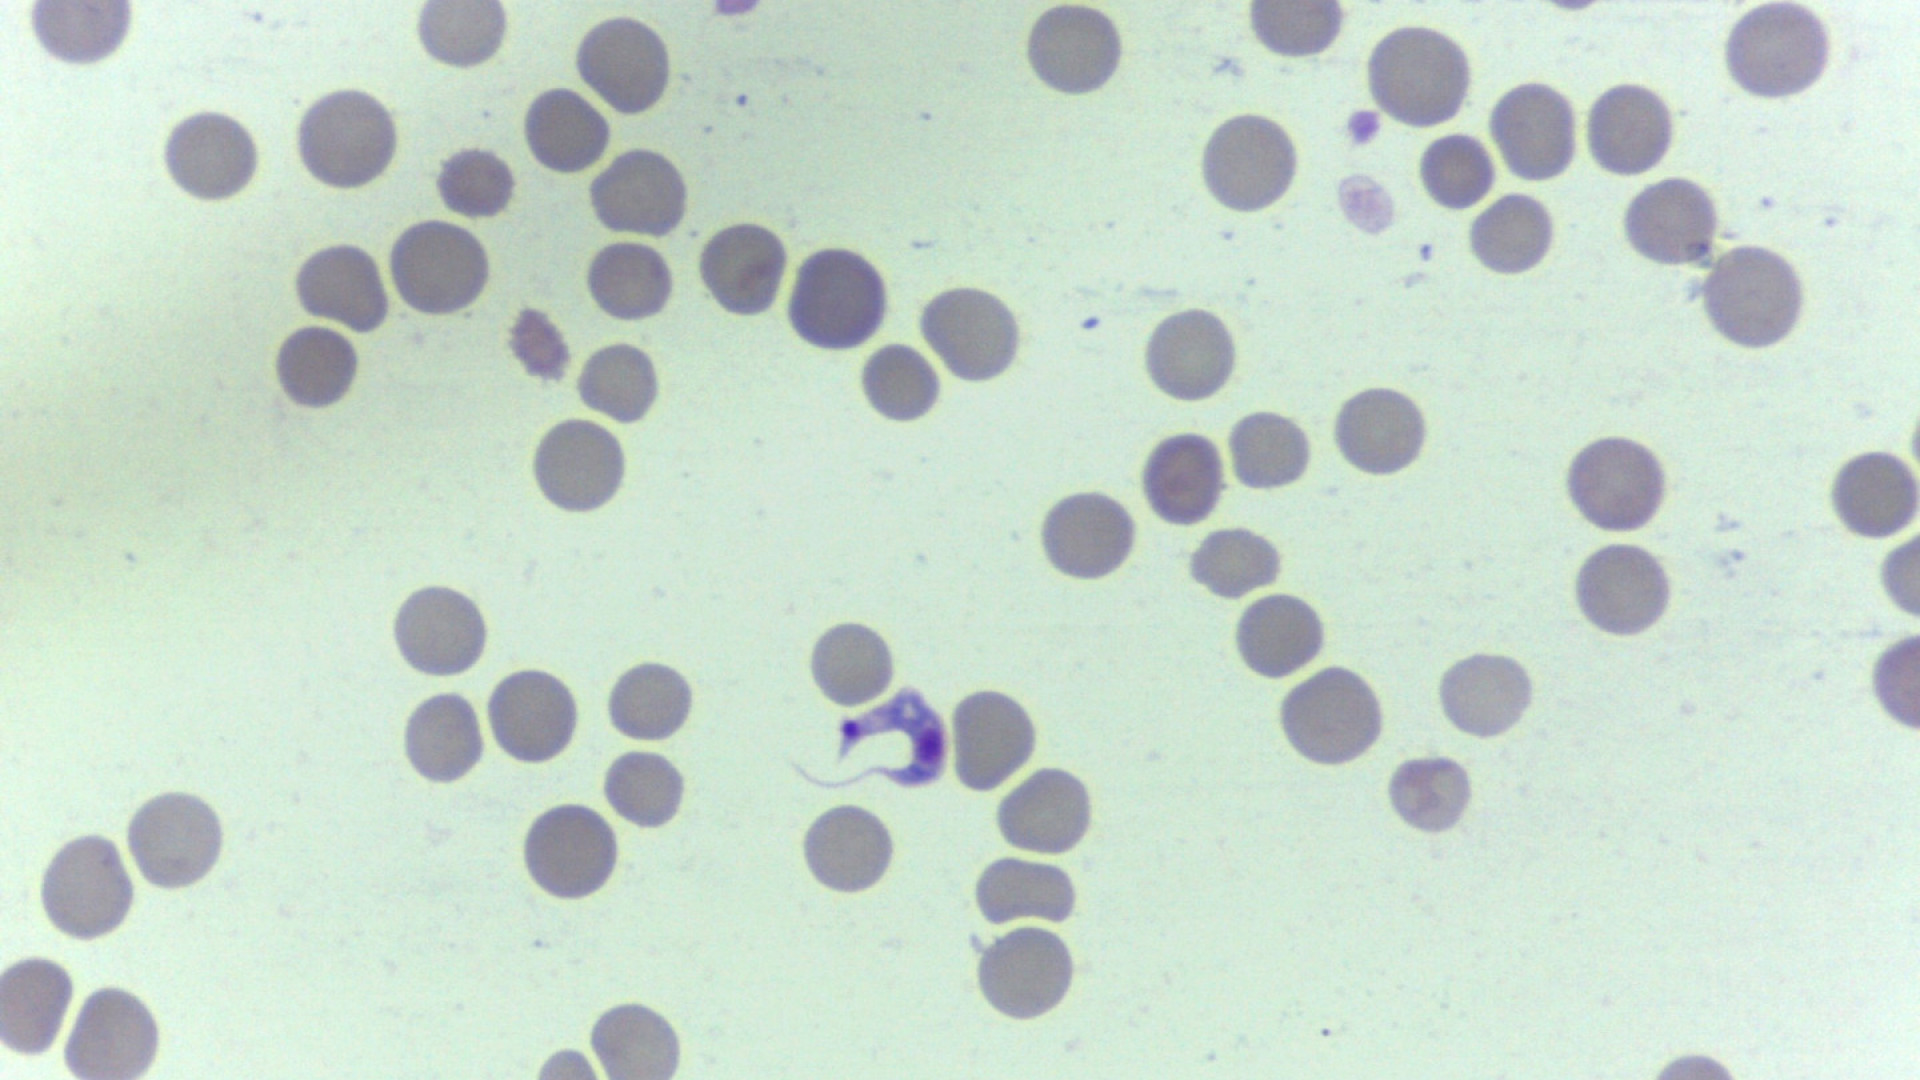

En un importante avance hacia el manejo y tratamiento del Chagas en Argentina, sociedades científicas y organizaciones han firmado un acta compromiso para fortalecer la atención integral.
La firma del acuerdo reunió a destacados actores en la sensibilización y abordaje de la problemática, con un enfoque prioritario y estratégico en infancia, adolescencia y personas con capacidad de gestar.
Adhieren al acta: Asociación Bioquímica Argentina (ABA), Drugs for Neglected Diseases initiative (DNDi), Federación Argentina de Cardiología (FAC), Fundación Mundo Sano (FMS), Grupo ¿De qué hablamos cuando hablamos de Chagas?, Hospital Materno Infantil Ramón Sardá, Sociedad Argentina de Cardiología (SAC), Sociedad Argentina de Infectología (SADI), Sociedad Argentina de Pediatría (SAP).
El Chagas, una enfermedad endémica en Argentina, afecta a aproximadamente 1,5 millones de personas. La mayoría de los casos se transmite de madre a hijo durante el embarazo, pero el 80 por ciento de los afectados no son diagnosticados ni reciben tratamiento adecuado.
Este acuerdo, coordinado por el Instituto Nacional de Parasitología “Dr. Mario Fatala Chaben“ de la ANLIS Malbrán, el Ministerio de Salud y la Organización Panamericana de la Salud (OPS), busca movilizar recursos y esfuerzos para mejorar el diagnóstico temprano y el acceso a tratamientos.
Las entidades firmantes se comprometen a intensificar sus acciones en sensibilización, prevención y atención integral de la problemática.
En este sentido, la directora del INP, Soledad Santini aseguró que “esta iniciativa permite un abordaje integral, con actores claves y el trabajo en conjunto facilita el camino para trabajar en la misma línea con un mismo objetivo”.
Además, agregó que "entendemos el gran desafío que conlleva abordar estas problemáticas sanitarias y esta acta pondera la implementación de manera integral que es clave para reducir la incidencia de esta enfermedad”.
0 Comentarios